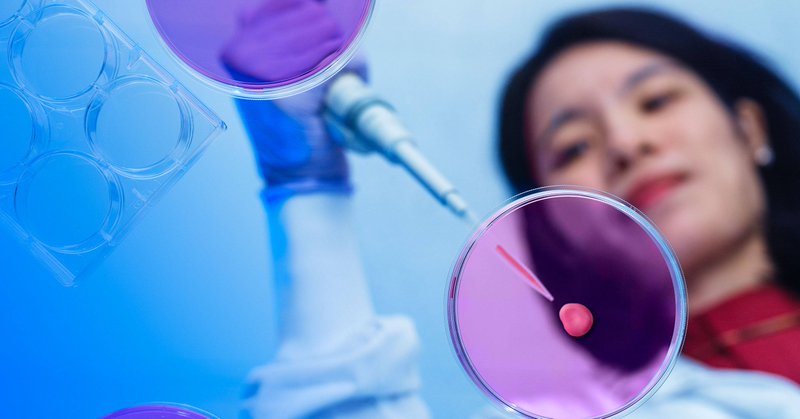
Tweet card summary image

Mayo Clinic
@MayoClinic
Followers
2M
Following
8K
Media
23K
Statuses
64K
An integrated clinical practice, education and research institution specializing in treating patients. Account maintained by @MayoClinic.
Minnesota, Florida, Arizona
Joined April 2008
For the 36th consecutive year since U.S. News & World Report launched its "Best Hospitals" rankings, Mayo Clinic again ranks at the top of the 2025–2026 list. Read more: https://t.co/mVhFe0Np7A
465
112
272
In Lusaka, Zambia, Mayo Clinic anesthesiologist Kashmira Chawla, M.D., led a group of senior residents from Mayo Clinic School of Graduate Medical Education on a collaborative expedition to improve airway management and perioperative care. Learn more: https://t.co/6XIpE6VYuA
0
1
8
From kefir to probiotic sodas, “gut health” drinks are everywhere. But do they really help your microbiome — or just your marketing feed? Dr. Lioudmila Karnatovskaia explains what actually works for gut health. https://t.co/wAGrcQrcq4
0
5
10
Only one week left to join the GivingTuesday Challenge! Your gift today can make 2X times the impact to help Mayo Clinic discover new treatments, improve care and save more lives. Give by December 2. https://t.co/KElxLBn4Us
#MayoClinic #GivingTuesday
0
5
7
Barbara Brown was working in New York City when the Sept. 11 attacks occurred. Exposure to toxins led to years of struggling to breathe and searching for answers. Barbara's journey led her to Mayo Clinic and, ultimately, a life-changing double-lung transplant.
2
6
22
Energy drinks may promise a quick boost — but what’s the real cost? Dr. Anna Svatikova, a Mayo Clinic cardiologist, joins On Nutrition to discuss how energy drinks affect your heart, brain, and sleep, and whether moderation is possible. 🎧 Listen to “Why energy drinks are more
1
7
17
When hormone therapy isn’t an option, women don’t have to suffer through menopause. Dr. Stephanie Faubion of Mayo Clinic’s Center for Women’s Health explains how lifestyle changes, plant-forward diets, and new nonhormonal treatments can help ease symptoms. @laura_ungar
apnews.com
Women experiencing hot flashes, night sweats and other menopausal symptoms don’t need to suffer. If doctors advise them to avoid hormone therapy because they’ve had a heart attack, blood clots,...
0
2
11
In this episode of Mayo Clinic’s Key in Quality podcast, experts talk about a new approach to helping patients in the bathroom. Is it possible to reduce falls and keep people safe without taking away independence? Tune in now. https://t.co/gn7iZA6OP9
2
4
12
Diabetes affects how the body uses glucose. It can mean that there is too much sugar in the blood. This can harm people in several ways. One serious complication is chronic kidney disease. Learn more: https://t.co/UwPKNEoybC
1
9
30
Clinicians typically classify meningiomas — the most common type of brain tumor — into three grades, ranging from slow-growing to aggressive. But a new multi-institutional study suggests that appearances may be deceiving. Learn more: https://t.co/h2AFt1OPYv
1
11
28
Healthy eating during the holidays isn’t about skipping cookies — it’s about balance. 🍽 Mayo Clinic’s Chef Jennifer Welper shares strategies to enjoy the season without feeling sluggish. What’s your favorite way to keep holiday meals balanced?
mcpress.mayoclinic.org
Healthy eating during the holidays can seem like an impossible assignment. From Thanksgiving onward, many Americans are inundated with family gatherings and holiday parties featuring…
0
3
13
Tiny “mini brains” grown from patients’ own cells are helping Mayo Clinic researchers unlock how addiction affects the brain — and how to treat it. https://t.co/cAftAzhtLJ
mayomagazine.mayoclinic.org
Transforming addiction treatment with organoid research.
2
12
14
At Mayo Clinic, people like Desiree embody what it means to combine purpose, compassion, and growth. Over the past decade, Desiree has built her career in transplant services, holding four roles across ambulatory and inpatient care. Each step has strengthened her ability to
0
5
12
Lung cancer remains the leading cause of cancer deaths, but early detection saves lives. Dr. @RManochakian, thoracic medical oncologist at Mayo Clinic, explains why getting screened is so important and which symptoms shouldn’t be ignored. Experts from the thoracic oncology and
1
6
25
While eye care and regular eye exams are important for everyone, they're particularly vital for people with diabetes. The blood vessels in the retina can be affected by diabetes, leading to a condition known as diabetic retinopathy. It can develop in anyone with type 1 or type 2
2
2
11
A major Mayo Clinic–led study shows that carotid artery stenting, combined with intensive medical therapy, lowers stroke risk for people with severe carotid artery narrowing, even without symptoms. Learn more: https://t.co/M2BxBzT7T7
#StrokeResearch #CREST2
0
18
46
As an Arizona Mayo Clinic transplant social worker, Joan Welty had seen firsthand how life-changing living kidney donation can be. In March 2024, she decided to step forward herself — donating one of her kidneys through a non-directed donation. Learn more about becoming a
1
4
21
The holidays are here, and sticking to healthy habits can be a challenge. Don't fall into the trap of expecting your routine to stay the same. Try these tips to maintain momentum: ▪️Define Success: What do you want to accomplish? ▪️Know Your 'Why': Why continuing your progress
1
7
18
Edwina Bhaskaran, M.S.N., R.N., Chief Clinical Systems and Informatics Officer at Mayo Clinic, has been recognized on Forbes’ 2025 list of next-generation chief information officers and tech leaders. Her journey from clinical nursing to leading system-wide innovation reflects
1
6
24
Mayo Clinic researchers are personalizing deep brain stimulation for epilepsy — mapping each patient's unique brain wave network to better target treatment. Learn more: https://t.co/1sLnvtFCFt
2
8
21
Are you serving as a wise mentor or a sideline spoiler at your child’s sports event? A Mayo Clinic specialist discusses how parents' behavior affects kids’ enjoyment and self-esteem. https://t.co/3qcN5s5WhH How do you balance wanting your child to excel with keeping sports fun?
1
5
11